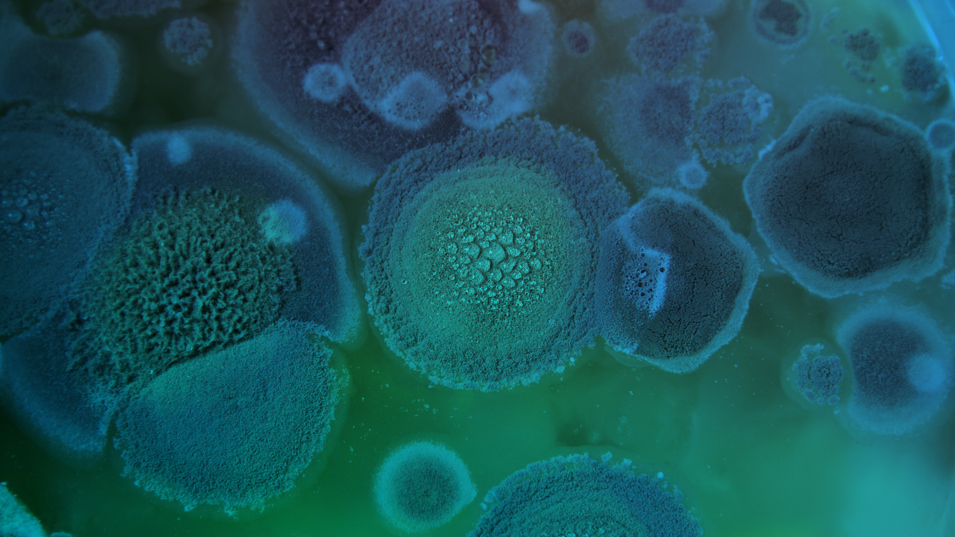
Forskere kortlægger resistente svampe

Svampe på arbejdet? Forskere kortlægger resistente svampe på danske arbejdspladser
Det Nationale Forskningscenter for Arbejdsmiljø 24-10-2024
Biomasse- og bioaffaldsanlæg, gartnerier og plejehjem er blandt de arbejdsmiljøer, som forskere fra NFA har undersøgt i et studie, der bygger på målinger taget over en 20-årig periode.
Ved du, hvad der er i luften på din arbejdsplads?
Forskere fra Det Nationale Forskningscenter for Arbejdsmiljø (NFA) har i over 20 år indsamlet prøver fra bl.a. gartnerier, biomasse- og bioaffaldsanlæg og hospitaler for at undersøge, i hvor høj grad arbejdsmiljøet kan føre til udsættelse for svampe gennem luften.
Visse svampetyper kan føre til infektioner, derfor har forskerne samtidig kigget på, om de undersøgte svampe kan være resistente mod forskellige typer af svampemidler.
Resultaterne er nu samlet i en rapport og udgør den første systematiske undersøgelse af udsættelse for resistente svampe i arbejdsmiljøet.
Flest svampe i luften på gartnerier, biomasse- og bioaffaldsanlæg
Forskerne har fokuseret på svampe, der kan vokse ved 37 grader, og undersøgt prøver fra en lang række arbejdspladser.
Her fandt de, at udsættelsen for svampe var meget lav på bl.a. plejehjem, hospitaler og spildevandsanlæg. På gartnerier, biomasse- og bioaffaldsanlæg var udsættelsen højere. Den højeste eksponering blev fundet for ansatte, der håndterer græsfrø, men dette var en ekstrem case med få målinger, som ikke afspejler det daglige arbejdsmiljø.
De så samtidig, at sammensætningen af svampeslægter og -arter varierede meget fra arbejdsmiljø til arbejdsmiljø. For eksempel fandt de ofte arten Aspergillus fumigatus på biomasse- og bioaffaldsanlæg, mens særligt slægten Penicillium var til stede i de undersøgte gartnerier. Mens Aspergillus fumigatus kan give infektioner, giver svampe inden for Pencillium kun meget sjældent infektioner.
Grafen viser udsættelse for svampe i de arbejdsmiljøer (undtagen græsfrø), som forskerne fra NFA undersøgte. Søjlerne svarer til den geometriske middelværdi af udsættelse (en slags gennemsnitlig koncentration af svampe per kubikmeter luft) i de undersøgte arbejdsmiljøer. Den sorte streg angiver standardafvigelsen og er et mål for, hvor meget eksponeringen varierer inden for et givent arbejdsmiljø.
Ingen stigning i resistens
Nogle svampe kan give infektioner hos mennesker, der i forvejen er sårbare og har et svagt immunforsvar. Det gælder blandt andet for Aspergillus fumigatus, der er den svampeart, som oftest forårsager alvorlige infektioner. Derfor er det vigtigt, at disse arter ikke udvikler resistens mod medicinsk behandling, og at de resistente svampe ikke spredes.
Udvikling af resistens over for svampemidler blandt potentielt sygdomsfremkaldende arter såsom arten Aspergillus fumigatus kan besværliggøre og forsinke behandling af infektioner.
Forskerne testede af den grund en række af de undersøgte svampearter for resistens mod nogle af de mest almindelige svampemidler. Her så de, at der i de fleste arbejdsmiljøerne fandtes resistente svampe. For Aspergillus fumigatus fandt de en samlet forekomst af resistens på 2.5 procent, hvilket umiddelbart ikke er højt.
- Vores undersøgelse viser, at det er muligt at blive udsat for resistente svampe gennem arbejdsmiljøet. Dog ser det ikke ud til at forekomsten af resistens er højere end i andre miljøprøver såsom i almindelig jord, siger ph.d.-studerende på NFA Victor Carp Koefod, der er førstefor-fatter på rapporten.
Svampene viste sig oftest at være resistente over for Itraconazol— et middel som har været anvendt i mange år. Forskerne fandt i mindre grad resistens over for de nyere svampemidler Voriconazol og Posaconazol. De fremhæver også, at de ikke fandt svampe, der var resistente over for alle de testede svampemidler.
Forekomsten af resistens var højest for svampearten Aspergillus niger, hvor 14.5 % af de testede svampe viste resistens mod ét eller flere svampemidler. Arten forårsager normalt ikke infektioner i mennesker. Derfor giver den højere forekomst af resistens ikke anledning til bekymring.
Samtidig kan forskerne heller ikke se nogen stigning i antallet af resistente svampe i de over 20 år, som de har indsamlet prøverne i.
Tøjskifte er en god ide
I rapporten er det ikke undersøgt, om medarbejderne på de undersøgte arbejdspladser risikerer at tage svampe med sig hjem efter fyraften. Tidligere studier fra NFA har dog vist, at svampe kan samle sig på arbejdstøjet igennem en arbejdsdag. Derfor kan for eksempel tøjskifte efter arbejde være et vigtigt tiltag til at forhindre, at svampene spredes.
- Vi har tidligere undersøgt skraldemænds arbejdsmiljø og på den baggrund kommet med en række anbefalinger til, hvordan de kan undgå at tage mikroorganismer som for eksempel svampe med sig hjem. Udover at skifte tøj efter fyraften, er det også en god ide at vaske hænder eller bruge håndsprit og sørge for at gøre godt rent på arbejdspladsen, fortæller seniorforsker på NFA Anne Mette Madsen, der er en af forskerne bag undersøgelsen.
Om studiet
- I projektet har forskerne undersøgt medarbejdere eksponering for resistente svampe igennem deres arbejde på tværs af forskellige arbejdsmiljøer, herunder biomasseanlæg, gartnerier, plejehjem og affaldshåndtering.
Sådan gjorde forskerne
Over 500 luftprøver taget med personbårne samplere igennem hele arbejdsdage blev undersøgt som en del af projektet. Potentielt infektiøse svampe blev udvalgt og testet for resistens imod tre azol-svampemidler, Itraconazol, Voriconazol og Posaconazol, samt polyen-svampemidlet Amphotericin B. Forekomsten af resistens er undersøgt i prøver indsamlet over en 20-årig periode.
Ekstern finansiering
Finansieret af Miljøstyrelsen
Styrker og svagheder ved studiet
En styrke ved studiet er dets størrelse, da der er analyseret over 500 prøver. Det er også en styrke, at prøverne er taget igennem hele arbejdsdage, hvor medarbejderne har bevæget sig rundt på deres arbejdspladser. Studiet har ikke kunnet påvise en stigning i resistens over tid, men på trods af det høje antal prøver kan det være svært at konkludere på udvikling over tid, fordi hyppigheden af forskellige arter fundet over tid også varier, og fordi nogle arter hyppigere er resistente end andre.